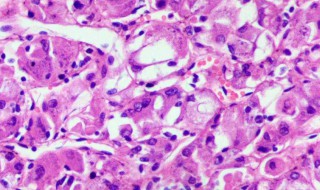
胞浆、嗜酸性细胞是什么意思 下面为大家讲解

1、胞浆(cytosol)是细胞质的一部分。胞浆+细胞器就是胞质,分布在细胞膜和细胞核之间,就像一个鸡蛋,壳是细胞膜,黄是细胞核,蛋清就是细胞质。细胞质大部分就是胞浆了,里边还有各式的细胞器来辅助完成细胞功能的。
2、嗜酸性细胞是腺垂体远侧部中的一类嗜色细胞,亦称Hiirthle细胞或Askanazy细胞。在正常甲状腺中约15%为此细胞。数量较多,约占远侧部腺细胞总数的40%。细胞呈现圆形或椭圆形,细胞体较大,胞质内含有嗜酸性颗粒。根据所分泌的激素不同可分为促生长激素细胞和促乳激素细胞。
综合百科2022-03-31 12:55:38未知
1、胞浆(cytosol)是细胞质的一部分。胞浆+细胞器就是胞质,分布在细胞膜和细胞核之间,就像一个鸡蛋,壳是细胞膜,黄是细胞核,蛋清就是细胞质。细胞质大部分就是胞浆了,里边还有各式的细胞器来辅助完成细胞功能的。
2、嗜酸性细胞是腺垂体远侧部中的一类嗜色细胞,亦称Hiirthle细胞或Askanazy细胞。在正常甲状腺中约15%为此细胞。数量较多,约占远侧部腺细胞总数的40%。细胞呈现圆形或椭圆形,细胞体较大,胞质内含有嗜酸性颗粒。根据所分泌的激素不同可分为促生长激素细胞和促乳激素细胞。